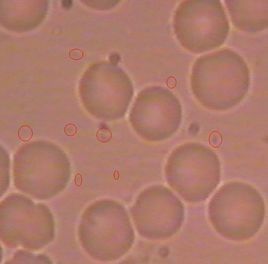
血液粘稠度

概念
血液的粘度是血液的理化特性之一液體的粘度來源於液體內部分子或顆粒間的摩擦,即內摩擦。如果以水的粘度為1,則全血的相對粘度為4~5,血漿的相對粘度為1.6~2.4(溫度為37℃時)。當溫度不變時,全血的粘度主要取決於血細胞比容的高低,血漿的粘度主要取決於血漿蛋白的含量。全血的粘度還受血流切率的影響。稠度高的表現
血液粘稠度午餐後犯困,需要睡一會兒,否則整個下午都無精打采。相反,晚餐後精神狀態特別好。
蹲著幹活氣喘。下蹲時回到心、腦的血液減少,肺、腦等器官缺血,導致呼吸困難。
陣發性視力模糊。血液變稠了,流速減慢,血液不能充分營養視神經。
稠度高的危害
若是血液變得粘稠,就會傷害到毛細血管,甚至堵塞毛細血管。如此一來,就不僅僅是氧氣和營養物質無法運送的問題了,連周邊的細胞都會死亡。而且肥大的血管很容易吸附脂肪、膽固醇、鈣等,由此血液會變得越發難以通過。放置不管的話,輕則可能引起頭痛,健忘,肩膀酸痛,腰痛,水腫,長斑,長皺紋,月經不調,痛經,脫髮,失眠,體寒等問題;還可能會加快動脈血管硬化,甚至引起腦梗塞和心肌梗塞等重大疾病。原因
負氧離子缺失
影響血液粘度的重要因素之一是紅細胞的分散態 ,它主要受紅細胞表面電荷量的影響,當表面負電荷量減少時,紅細胞易於聚集成“紙錢樣”,使血粘度增高,即所謂“電粘度效應”。負氧離子自身的負電荷能影響血液的膠體和電代謝過程,使血中等電離子的組成和分布發生變化 ,可改善血細胞的分散態 。血沉與紅細胞的分散態有關,能部分反映紅細胞表面帶電荷的情況 。負氧離子即不稀釋血液,又不降低纖維蛋白原的含量,它以帶電粒子作用於機體 。負氧離子能非常顯著地降低血粘度,並且與血沉的變化成正相關,說明它是通過帶電離子的作用 。增加了紅細胞的表面負電荷,改善了紅細胞的分散態,使血粘度降低。
食物
血液粘稠度運動不足
運動不足導致體內的脂肪和糖分燃燒不充分,最終變成脂肪在體內囤積起來。另外,運動不足導致代謝機能下降,殘留在體內的廢物不能及時被排出也會導致血液變得粘稠。壓力
長期處於壓力大的狀態不但會使血壓上升,連膽固醇和血糖值也會上升,這樣就導致血液流通不暢,最終血液變得粘稠。飲酒和吸菸
過度飲酒和吸菸不但產生使身體“生鏽”的活性氧(在生物體內直接或間接地損傷細胞,是形成老化的一個原因),還會增加膽固醇和中性脂肪,導致血液粘稠。活性氧除了會手飲酒和吸菸的影響之外,也受到紫外線、壓力、環境激素(在土壤、大氣等環境中具有存在,進入生物體內會造成激素分泌失調的化學物質)等的影響。若是活性氧在體內累積過多,會使身體的血液呈現酸性,加速老化。水分不足
大量出汗導致體內水分不足,而血液中的水分也會變得不足。當天氣炎熱,或者感冒發燒時很容易引起脫水時,在這些情況下血液就容易變粘稠。降粘稠度方法
不要吃得太多
血液粘稠度適當的運動
如果定期進行像步行和游泳這樣不會給身體帶來負擔的輕運動的話,會使全身血液暢通,這樣就能改善血液粘稠的狀況了。但是運動過後會大量地失去水分而容易造成血液變得粘稠,所以千萬不要忘記運動後要適時補充水分。釋放壓力
有壓力就要以各種方式儘快排散出去,聽歌,玩遊戲,打球,散步,大笑,找朋友傾訴等等,每天要讓自己的心情爽朗沒負擔,這樣不但血液不容易變粘稠,還可以預防亞健康呢。每天洗澡
在38度到41度的熱水澡中,一整天的身心疲憊都被沖刷乾淨,血液也變得暢通起來,這樣就會稀釋粘稠的血液。但是,注意不要突然洗太熱的熱水澡,否則容易得血栓,也可能有心肌梗塞和腦中風的危險。水分補給
一是要掌握時機。早晨起床後、三餐前(飯前1小時)和就寢前,最好飲水200毫升。二是應該飲用稀釋效果較好的水。鹽水會促進細胞脫水,不足取;冷水會刺激胃腸血管收縮,有礙水的吸收,不宜飲;純淨水因為太“純”,其低滲狀態會使水很快進入細胞內,對稀釋血液也不理想。理想的水應是20℃—25℃的白開水,其張力、密度等都接近血液和組織細胞 。推薦飲食
苦瓜
血液粘稠度提示:慢性腸炎患者不宜多食苦瓜,食用時宜急火快炒,不宜長時間的燉煮。
芹菜
中醫認為芹菜性涼。芹菜含有豐富的維生素和礦物質,能增強胃腸蠕動,有很好的通便作用,能幫助排除腸道中多餘的脂肪。國外已有研究證實,經常食用芹菜的人,體內膽固醇的含量顯著下降,而且還能明顯的降低血壓。提示:消化道不好的老年人不宜多食用芹菜。
辣椒
辣椒含維生素C的比例在所有食物中最高。維生素C可以改善機體微循環,減低毛細血管脆性,同時維生素C還能夠降低膽固醇的含量,是一種天然的降脂食物。日本學者發現,辣椒素調味能促進脂肪的新陳代謝,防止體內脂肪的積存,因而有降脂和減肥的功效。提示:過量食用辣椒會刺激胃腸道黏膜,容易引發胃痛、胃潰瘍等疾病。此外,辣椒屬於大熱之品,故中醫認為高血壓患者應慎用辣椒。
大蒜
大蒜具有明顯的降血脂和預防動脈硬化的作用,並能有效防止血栓形成。經常食用大蒜,能夠對心血管產生顯著的保護作用。大蒜又被稱為“藥用植物中的黃金”。提示:醃製大蒜時間不宜過長,以免有效成分遭到破壞。患有消化道疾病、肝病及眼病的患者不宜過多食用。
菜花
菜花有白、綠兩種,綠色的也叫花椰菜。兩者的營養價值基本相同,菜花熱量低,食物纖維含量很高,還含有豐富的維生素和礦物質,因此它又被稱為“天賜的良藥”。菜花含類黃酮較多。而類黃酮是一種良好的血管清理劑,能有效的清除血管上沉積的膽固醇,還能防止血小板的凝集,減少心臟病的發生。提示:蒸食是食用菜花的最佳方式。將菜花在鹽水中浸泡幾分鐘,菜蟲就會從其中跑出來,而且還可以祛除殘留的農藥
茄子
茄子皮內含有豐富的維生素P,有顯著的降低血脂和膽固醇的功能。維生素P還可以增加毛細血管的彈性,改善微循環,具有明顯的活血、通脈功能。此外,茄子中還含有大量的皂草甙,也能降低血液中的膽固醇。因此,茄子對於高血壓、動脈硬化的患者來說是理想的食物。提示:油炸茄子會使維生素P大量丟失,因此應減少油炸,或在其表面掛糊上漿後再炸。